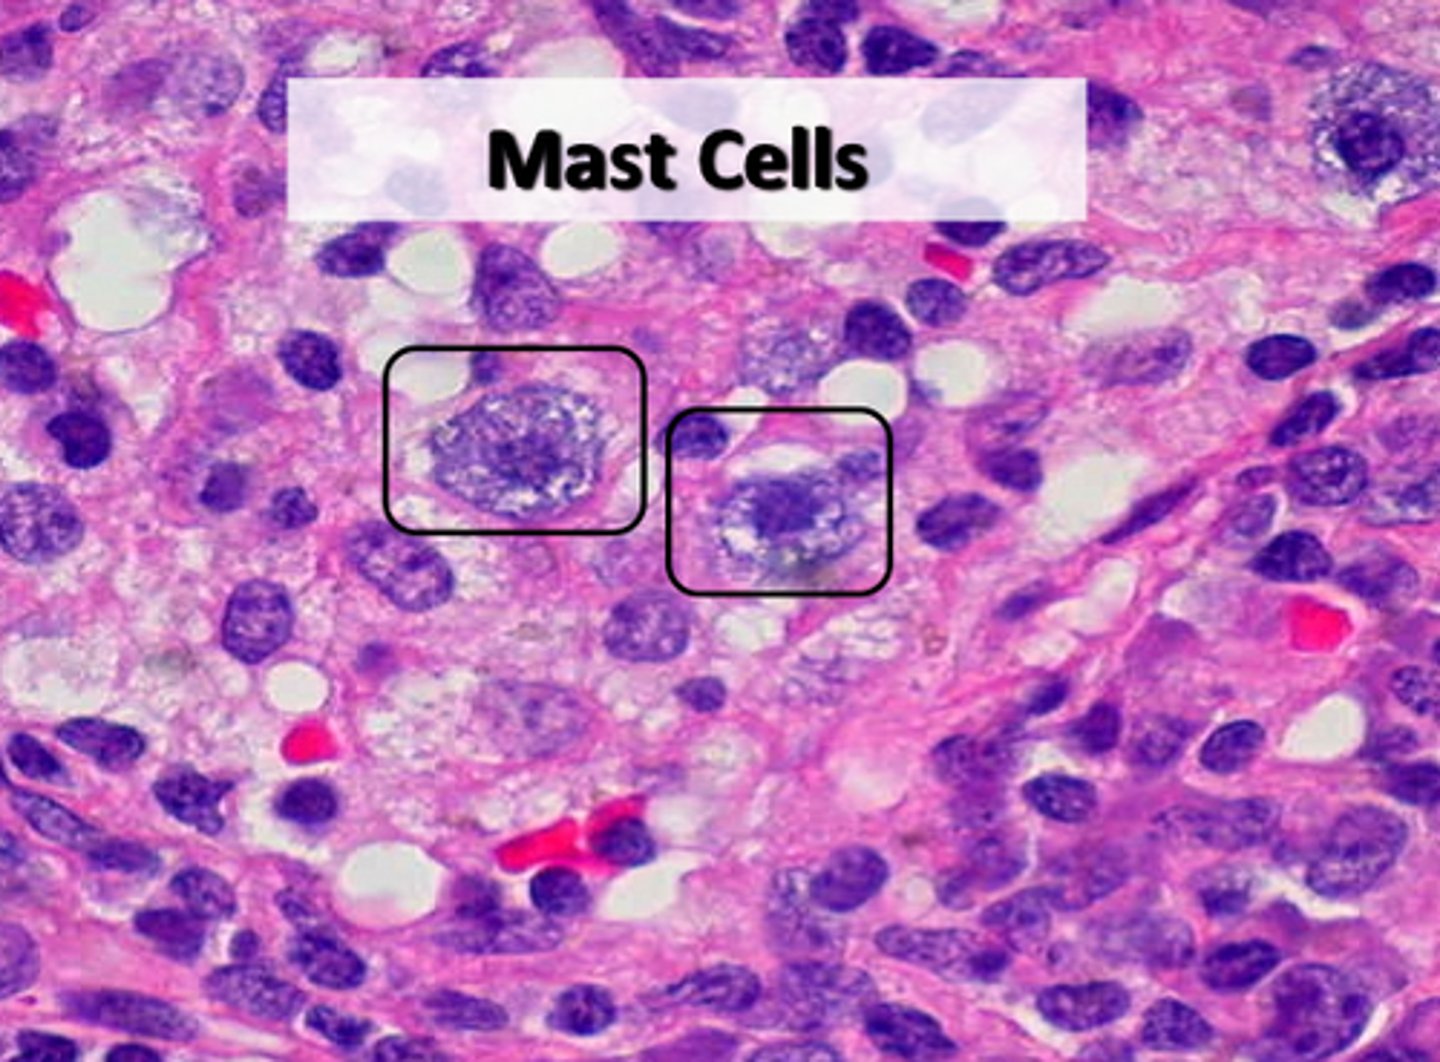
<p>small, mobile cells found near blood vessels; secrete histamine and heparin to stimulate local inflammation in response to injury/infection</p>

1/78
Looks like no tags are added yet.
Name | Mastery | Learn | Test | Matching | Spaced | Call with Kai |
|---|
No study sessions yet.
Connective Tissue
Cells are separated by a matrix of loosely or densely packed intercellular material. The matrix consists of fibers and of loose or dense ground substance

Wandering cells
Free macrophages, mast cells, lymphocytes, and microphages

free macrophages
ike fixed macrophages but are free to circulate throughout connective tissues. When within the blood are called monocytes

Mast cells
small, mobile cells found near blood vessels; secrete histamine and heparin to stimulate local inflammation in response to injury/infection
Lymphocytes
migrate throughout body and increase in number where tissue damage occurs; can develop into plasma cells which produce antibodies.

Microphages (e.g. neutrophils and eosinophils):
migrate throughout body and respond tochemicals released by macrophages and mast cells. These cells are also phagocytic.

FIXED CELLS
Fibroblasts
Fixed macrophages
Adipocytes
Mesenchymal cells
Melanocytes

Fibroblasts
most abundant, large, star-shaped, produce fibers

Fixed macrophages
irregularly shaped and utilized to engulf invaders and damaged cells.

Adipocytes
Fat cells, number varies between types of connective tissues

Mesenchymal cells
stem cells, respond to local injury or infection by dividing to produce new cells
Melanocytes
produce melanin (a dark brown pigment); common inepithelial tissue but also found in connective tissue; gives tissue a dark color and differs in number in individuals.

Connective Tissue Fibers
collagen fibers, elastic fibers, reticular fibers
collagen fibers
Relatively thick, thread-like, composed of collagen and occurring in long, parallel bundles. It can withstand much force when pulled along axis. (Note: do not stain well and are difficult to distinguish in light microscopy
elastic fibers
Thinner and form complex networks; branched. Return to original length after stretching
reticular fibers
Highly branched and delicate supporting networks. Able to resist forces applied from many directions
Classification of Connective Tissues
Connective Tissue Properโ2 subclasses
Cartilage
Bone
Blood
Lymph
connective tissue proper
loose connective tissue and dense connective tissue
loose connective tissue
areolar Connective Tissue, adipose Connective Tissue, reticular Connective Tissue
areolar connective tissue
Found below the epithelium in most parts of the body. Made up of mostly fibroblasts with elastic and collagenous fibers

adipose connective tissue
Has modified fibroblasts that store fat and thus become swollen, pushing the nucleus to the edge of the cell. Widely distributed throughout the body

reticular connective tissue
Resembles areolar tissue but the matrix is made up of only reticular fibers. Found in bone marrow, spleen, liver, and lymph nodes

dense connective tissue
dense regular connective tissue, dense irregular connective tissue, elastic connective tissue
dense regular connective tissue
Thickly packed collagenous fibers in a regular, parallel arrangement. Contains fibroblasts and a few elastic fibers. Found in tendons, ligaments, aponeuroses, and covering skeletal muscle (deep fasciae)

dense irregular connective tissue
Resembles dense regular connective tissue except that the collagenous fibers are irregularly arranged. Also contains fibroblasts and a few elastic fibers. Found in fibrous capsules of organs and joints, periostea, perichondria, nerve, and muscle sheaths, and makes up the dermis

elastic connective tissue
Elastic fibers are predominant with fibroblasts embedded in between. Found in the walls of the aorta and other blood vessels, in the vocal cords, surrounding respiratory passages, and ligamenta flava and ligamentum nuchae of the spinal column. Often underlies transitional epithelium.

Cartilage
A supporting connective tissue. Made up of chondrocytes (cartilage cells) surrounded by a semisolid gel-like matrix. Avascular. (note the presence of chondrocytes within lacunae) (hyaline, fibrocartilage, and elastic)

Hyaline Cartilage
Matrix of tightly packed collagen fibers not easily seen under the light microscope. It has a clear, glassy appearance. Found in the tracheal rings, costal cartilages of the ribs, cartilage of the nose, larynx, and covers bone surfaces at synovial joints. Tough but flexible

elastic cartilage
Matrix is supported by elastic fibers, which make it resilient and flexible, are less densely packed, and are arranged irregularly. Found in the pinna, epiglottis, auditory canal, and tip of the nose.

Fibrocartilage
Matrix is supported by collagenous fibers, which are densely packed and regularly arranged. Found in intervertebral discs, makes up the menisci of the knee join,t and in the symphysis pubis. Very tough and durable

Bone
a supporting connective tissue; one-third of its matrix consists of collagenous fibers.
Blood
a fluid connective tissue.

Lymph
also considered a fluid connective tissue
Thin skin layers
stratum corneum, stratum granulosum, stratum spinosum, stratum basale

Thick skin layers
stratum corneum, stratum lucidum, stratum granulosum, stratum spinosum, stratum basale

Stratum basale or Stratum germinativum
deepest or basal layer that continually multiplies to replenish cells lost from the epidermal surface

Stratum spinosum
a layer of the epidermis that provides strength and flexibility to the skin

Stratum granulosum
a layer of the epidermis that marks the transition between the deeper, metabolically active strata and the dead cells of the more superficial strata

Stratum lucidum
a layer of the epidermis found only in the thick skin of the fingers, palms, and soles

Stratum corneum.
the most superficial layer of the epidermis consisting of dead cells

Carotene vs Melanin
melanin is in the epidermis of the skin, carotene is in the dermis; high melanin rate = darker brown to black skin tones, high carotene rate = yellow to reddish tones
Dermis
middle layer of skin - Divided into a papillary and reticular region
papillary region of dermis
areolar connective tissue layer beneath basement membrane

reticular region of dermis
Attached to subcutaneous layer, bundles of thick collagen fibers, wandering macrophages and other floating cells, fibroblasts; some adipose cells in the deepest layers; coarse elastic fibers; collagen fibers form a weave network that is more regular than the papillary region (helps resist skin stretching); blood vessels, nerves, sebaceous (oil) glands, suderiferous (sweat) glands occupy spaces between fibers; combination of collagen and elastic fibers provide the skin strength, extensibility, elasticity

dermal papillae
a fingerlike projection of the dermis that may contain blood capillaries or Meissner corpuscles (of touch)

sebaceous glands
secrete sebum (oil) into the hair follicles where the hair shafts pass through the dermis

apocrine sudoriferous glands
Sweat gland, regulated by hormones, not activated until puberty, found in axilla and groin, gives body odor

eccrine sudoriferous glands
the major sweat glands of the human body, found in virtually all skin, with the highest density in palms and soles, then on the head, but much less on the trunk and the extremities.

hair follicle
sac within which each hair grows

hair shaft
visible part of the hair

vellus hair
pale, fine body hair of children and adult females

terminal hair
Long, coarse, pigmented hair found on the scalp, legs, arms, and bodies of males and females.

arrector pili muscle
An involuntary muscle fiber attached to the underside & base of the hair follicle

Pacinian corpuscle
touch receptor that detects deep pressure and vibrations

Ruffini corpuscle
detects continuous pressure and stretching

Meissner corpuscle
a tactile nerve ending receptor in the dermal papillae that is sensitive to touch

Merkel cells
detects fine touch and light pressure (between epidermis and dermis)

acne
inflammatory disease of the skin involving the sebaceous glands and hair follicles

actinic keratosis
a precancerous skin growth that occurs on sun-damaged skin

1st degree burn
Only the epidermis (red, painful, and edema)

2nd degree burn
epidermis and part of dermis (blistered)

3rd degree burn
All three layers have been effected

callus
area of thick hard skin

blisters
a small bubble on the skin filled with serum and caused by friction, burning, or other damage.

cold sores
small fluid-filled blisters that itch and sting, caused by a herpes simplex infection

Cyanosis
bluish discoloration of the skin

decubitis ulcers
Bedsores caused by problems with dermal circulation.
Caused by compression of superficial blood vessels
Sores most common on skin covering joints or bony prominences
Affects epidermis and dermis
Kills epithelial cells (easier for bacteria to invade)
Erodes dermal tissues

dermatitis
inflammation of the skin

Impetigo
bacterial skin infection characterized by isolated pustules that become crusted and rupture

Psoriasis
chronic skin condition producing red lesions covered with silvery scales

Rosacea
Chronic skin disorder of the face with red inflamed areas appearing mostly on the nose and cheeks

scurvy
a disease caused by lack of vitamin C

basal cell carcinoma
Most common and least severe type of skin cancer; often characterized by light or pearly nodules.
-starts at the deepest layer of the epidermis. shiny, ooze, grow slowly, no metastasis

squamous cell carcinoma
malignant tumor of the squamous epithelial cells in the epidermis
-irregular formation, rapid multiplication, metastasis

malignant melanoma
Most serious form of skin cancer; often characterized by black or dark brown patches on the skin that may appear uneven in texture, jagged, or raised.

skin grafts
Pieces of skin that are cut from one part of a person's body and moved to the injured area

transdermal patch delivery
drug molecules diffuse through the epidermis to the blood vessels in the dermal layer

Vitiligo
localized loss of skin pigmentation characterized by milk-white patches

Stratum germinativum
also known as the basal cell layer, the deepest live layer of the epidermis that produces new epidermal skin cells and is responsible for growth
